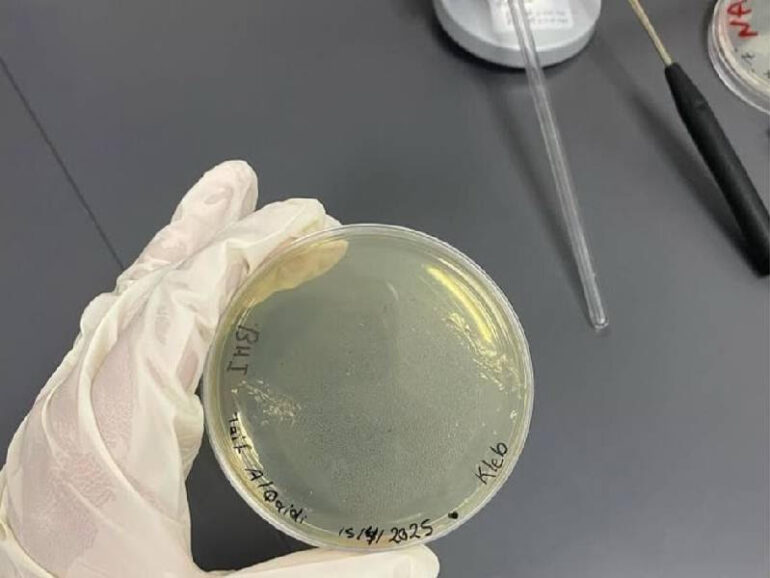

By OUR CORRESPONDENT
By OUR CORRESPONDENT
Muscat – Tifa Obaid al Qaydi, a student at the University of Sharqiyah, has developed a scientific project to treat cancer using genetically modified bacteria.
Her innovation secured her first place in the national round of the Falling Walls Lab competition, earning her the opportunity to represent Oman at the global finale in Berlin this November.
The project, titled ‘Treating Cancer Using Bacteria’, employs genetically engineered bacteria as a targeted delivery system to attack the tumour microenvironment from within. This can be achieved either by releasing anti-cancer compounds or by stimulating the immune system to fight the tumour directly.
Tifa explained that her research aims to create a precise therapy targeting only cancer cells while minimising the side effects commonly associated with chemotherapy.

“The goal is to ensure that healthy cells remain unharmed, increasing the chances of controlling or shrinking tumours and offering new hope for patients whose conditions do not respond to conventional treatments,” she said.
Highlighting the uniqueness of the project, Tifa informed that it uses ‘smart microorganisms’ as an alternative to chemical or radiation-based therapies.
By combining biological therapy with genetic engineering, the project opens the way for personalised treatments tailored to the characteristics of each patient’s tumour.
Looking ahead, Tifa aims to develop a prototype suitable for clinical trials, collaborate with international research institutions to validate the treatment’s efficacy and safety, and expand the research to address multiple types of cancer.
Her ultimate goal is to register a patent, marking a significant Omani contribution to the global fight against cancer.
© 2021 Apex Press and Publishing. All Rights Reserved. Powered by Mesdac